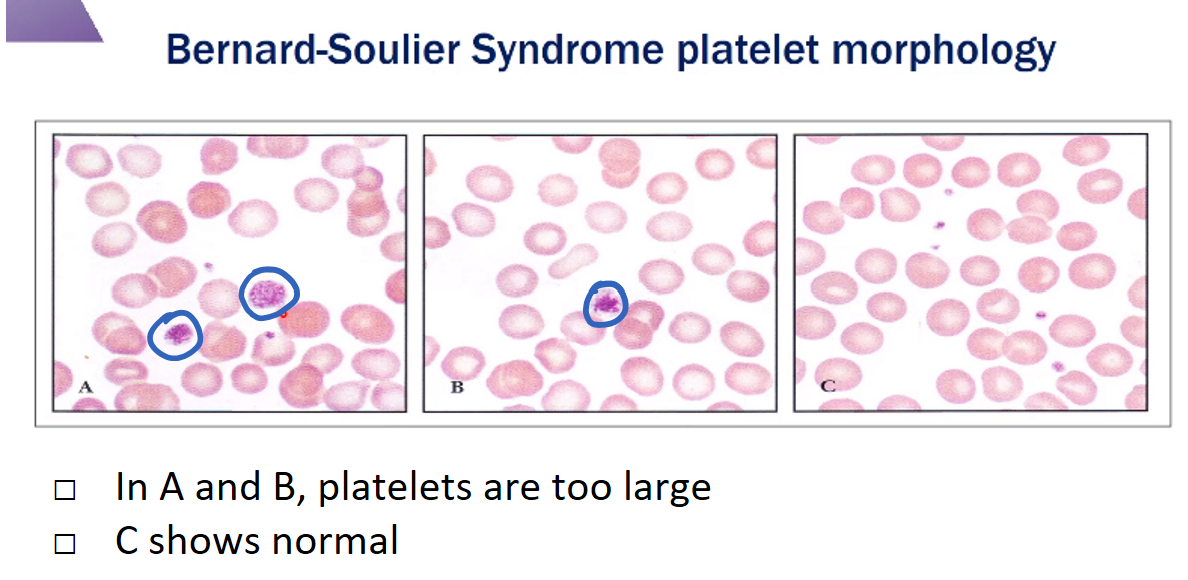

How does Wiskott-Aldrich syndrome affect the platelet life cycle?
Interferes with platelet production
The Wiskott-Aldrich protein (WASp) is supposed to stabilize the platelet cytoskelton
Mutation -> impaired platelet production
Does antiplatelet therapy (aspirin) help more in arterial or venous thrombus?
Arterial
In venous thrombus, platelets play a role but various RBCs and other factors are also important

When during primary hemostasis do platelets release thromboxane A2 and ADP?
What is their function?
When they are activated
They amplify platelet activation
- Platelet activation*
- -> Activates PL2*
- -> Produces arachadonic acid*
- ->>> COX pathway produces thromboxane A2*

What is the primary symptom of a qualitative platelet defect?
Skin and mucocutaneous bleeding
If a platelet is not consumed during a clotting event, how does it know when it’s time to die?
Intrinsic mitochondrial pathway
- Caspases
- -> change in platelet membrane; phosphatidyl serine comes outside
- Marks the platelet for apoptosis

C - Glanzmann Thrombasthenia
- Glanzmann:
- Aggregation with ristocetin
- No aggregation with ADP, epinephrine, collagen, arachadonic acid
- Bernard-Soulier:
- No aggregation with ristocetin
- Aggregation with everything else
What substance drives platelet development?
Thrombopoietin
What receptor on platelets binds to vWF?
GPIb
Which platelet disorder will have thrombocytopenia with large platelets?
Bernard-Soullier syndrome
- Defect in GPIb*
- No aggregation with ristocetin*
Do white blood cells play a larger role in arterial or venous thrombosis?
Venous
After platelet activation (binding to collagen and vWF on the injured endothelium), list the remaining steps of primary hemostasis
- Platelet granule release (ADP)
- Thromboxane A2 synthesis (via COX pathway)
- Expresses GPIIb/IIIa to bind fibrinogen
- Expresses phosphatidyl serine so that clotting factors can assemble
After primary hemostasis, the area has a platelet plug and is set up for secondary hemostasis - the clotting cascade (thrombin generation to cleave fibrinogen -> fibrin)
What platelet receptor is defective in Glanzmann’s Thrombasthenia?
GBIIb/IIIa
Severe bleeding disorder in childhood
What is the average platelet lifespan?
8-10 days
Which of the following will have normal aggregation with ristocetin?
- Glanzmann thrombasthenia
- Bernard-Soullier
Glanzmann thrombasthenia
- But abnormal with other facotrs*
- Bernard-Soullier is opposite; normal with ADP, epinephrine, collagen, arachadonic acid, but no aggregation with ristocetin*
What platelet receptor is defective in Bernard-Soulier syndrome?
GB1b
What is the morphological difference between a platelet with granule deficiency and one that is normal but exhausted (used up)?
Exhausted platelet will have podocytes
Both will have absent granules

When during primary hemostatsis do platelets express GPIIb/IIIa receptors?
What do these receptors bind?
After activation and conformational change, platelets express GPIIb/IIIa
Binds fibrinogen
Leads to platelet aggregation
Also express anionic phospholipids (phosphatidyl serine) - basically a staging area where coagulation factors can assemble and activate fibrinogen -> fibrin
After endothelial injury, platelets bind to two endothelial substances and tether themselves to the site of injury
What are the two substances?
vWF
Collagen
First rolling, then tight adhesion

Which cells produce platelets?
Where?
Megakaryocytes
Bone marrow
Each megakaryocyte can produce 100’s-1000’s of platelets


